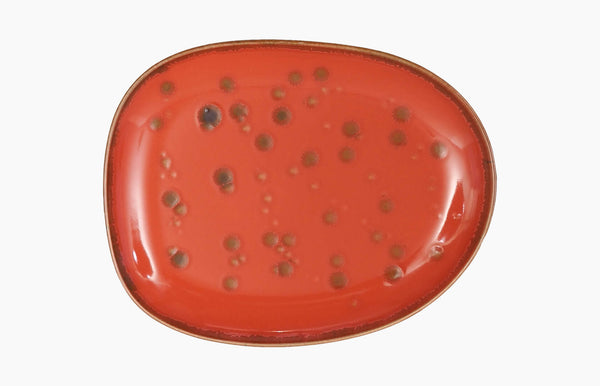
Small Plate 22x18cm

Joy and personality at the table
Mature is the ultimate exponent of warmth and a tribute to clay, one of the raw materials of the porcelain product.
Under a brown and orange-shaded glaze, worked with reactive elements, Mature is a collection with life and full of personality, by taking us back, at the same time, to more rustic and equally elegant surroundings.
The colour, also known as terracotta, represents joy and vitality, energy and prosperity, while being strongly associated with creativity.
Mature is, thus, the result of multidisciplinary team’s creativity, able to reproduce this sense and concept in porcelain, developed in the Isola collection, a markedly organic and quite elegant form, with a contemporary and global sense.

The long plate 32x14cm is a great option to serve your dishes. This piece with its longed and round shape that is less conventional enables you to shine at your dining experiences.
Enhance your creative spirit and light it up with the terracota colour with shinny glased details.

The square plate 26cm can serve many purposes. From dining plate to serving plate. This piece has a lot of potential, with hits squared shape it creates the perfect canvas for the creative mind to plate.
The colour, also known as terracotta, represents joy and vitality, energy and prosperity. Enhance your creative spirit and light it up with the perfect plate for your plating.

The Medium Dip Bowl can play many roles. From Dessert plate, butter or jam plate. This piece enables the creativity of the plating master.
Enhance your creative spirit and light it up with the terracota colour with shinny glased details.

The Mature bowl can be used to serve your delightful soup or for granola bowl for example. This piece with it's unconventional form allows for very creative and colourfull contrasts.
Have fun creating tasty recipees and using this great piece of design to decorate your creations.